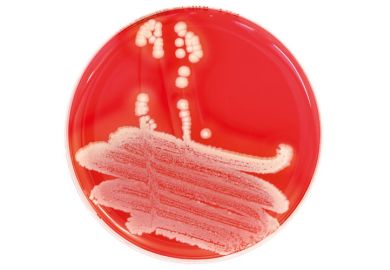
Close-up of petri dish

Research funding
Latest news and analysis on research funding and funders, including coverage of UK research councils, including UK Research and Innovation, US funders, European funders including the European Research Council, and international agencies. Topics covered include budgets, grant applications, research assessment, doctoral funding and international research collaboration.